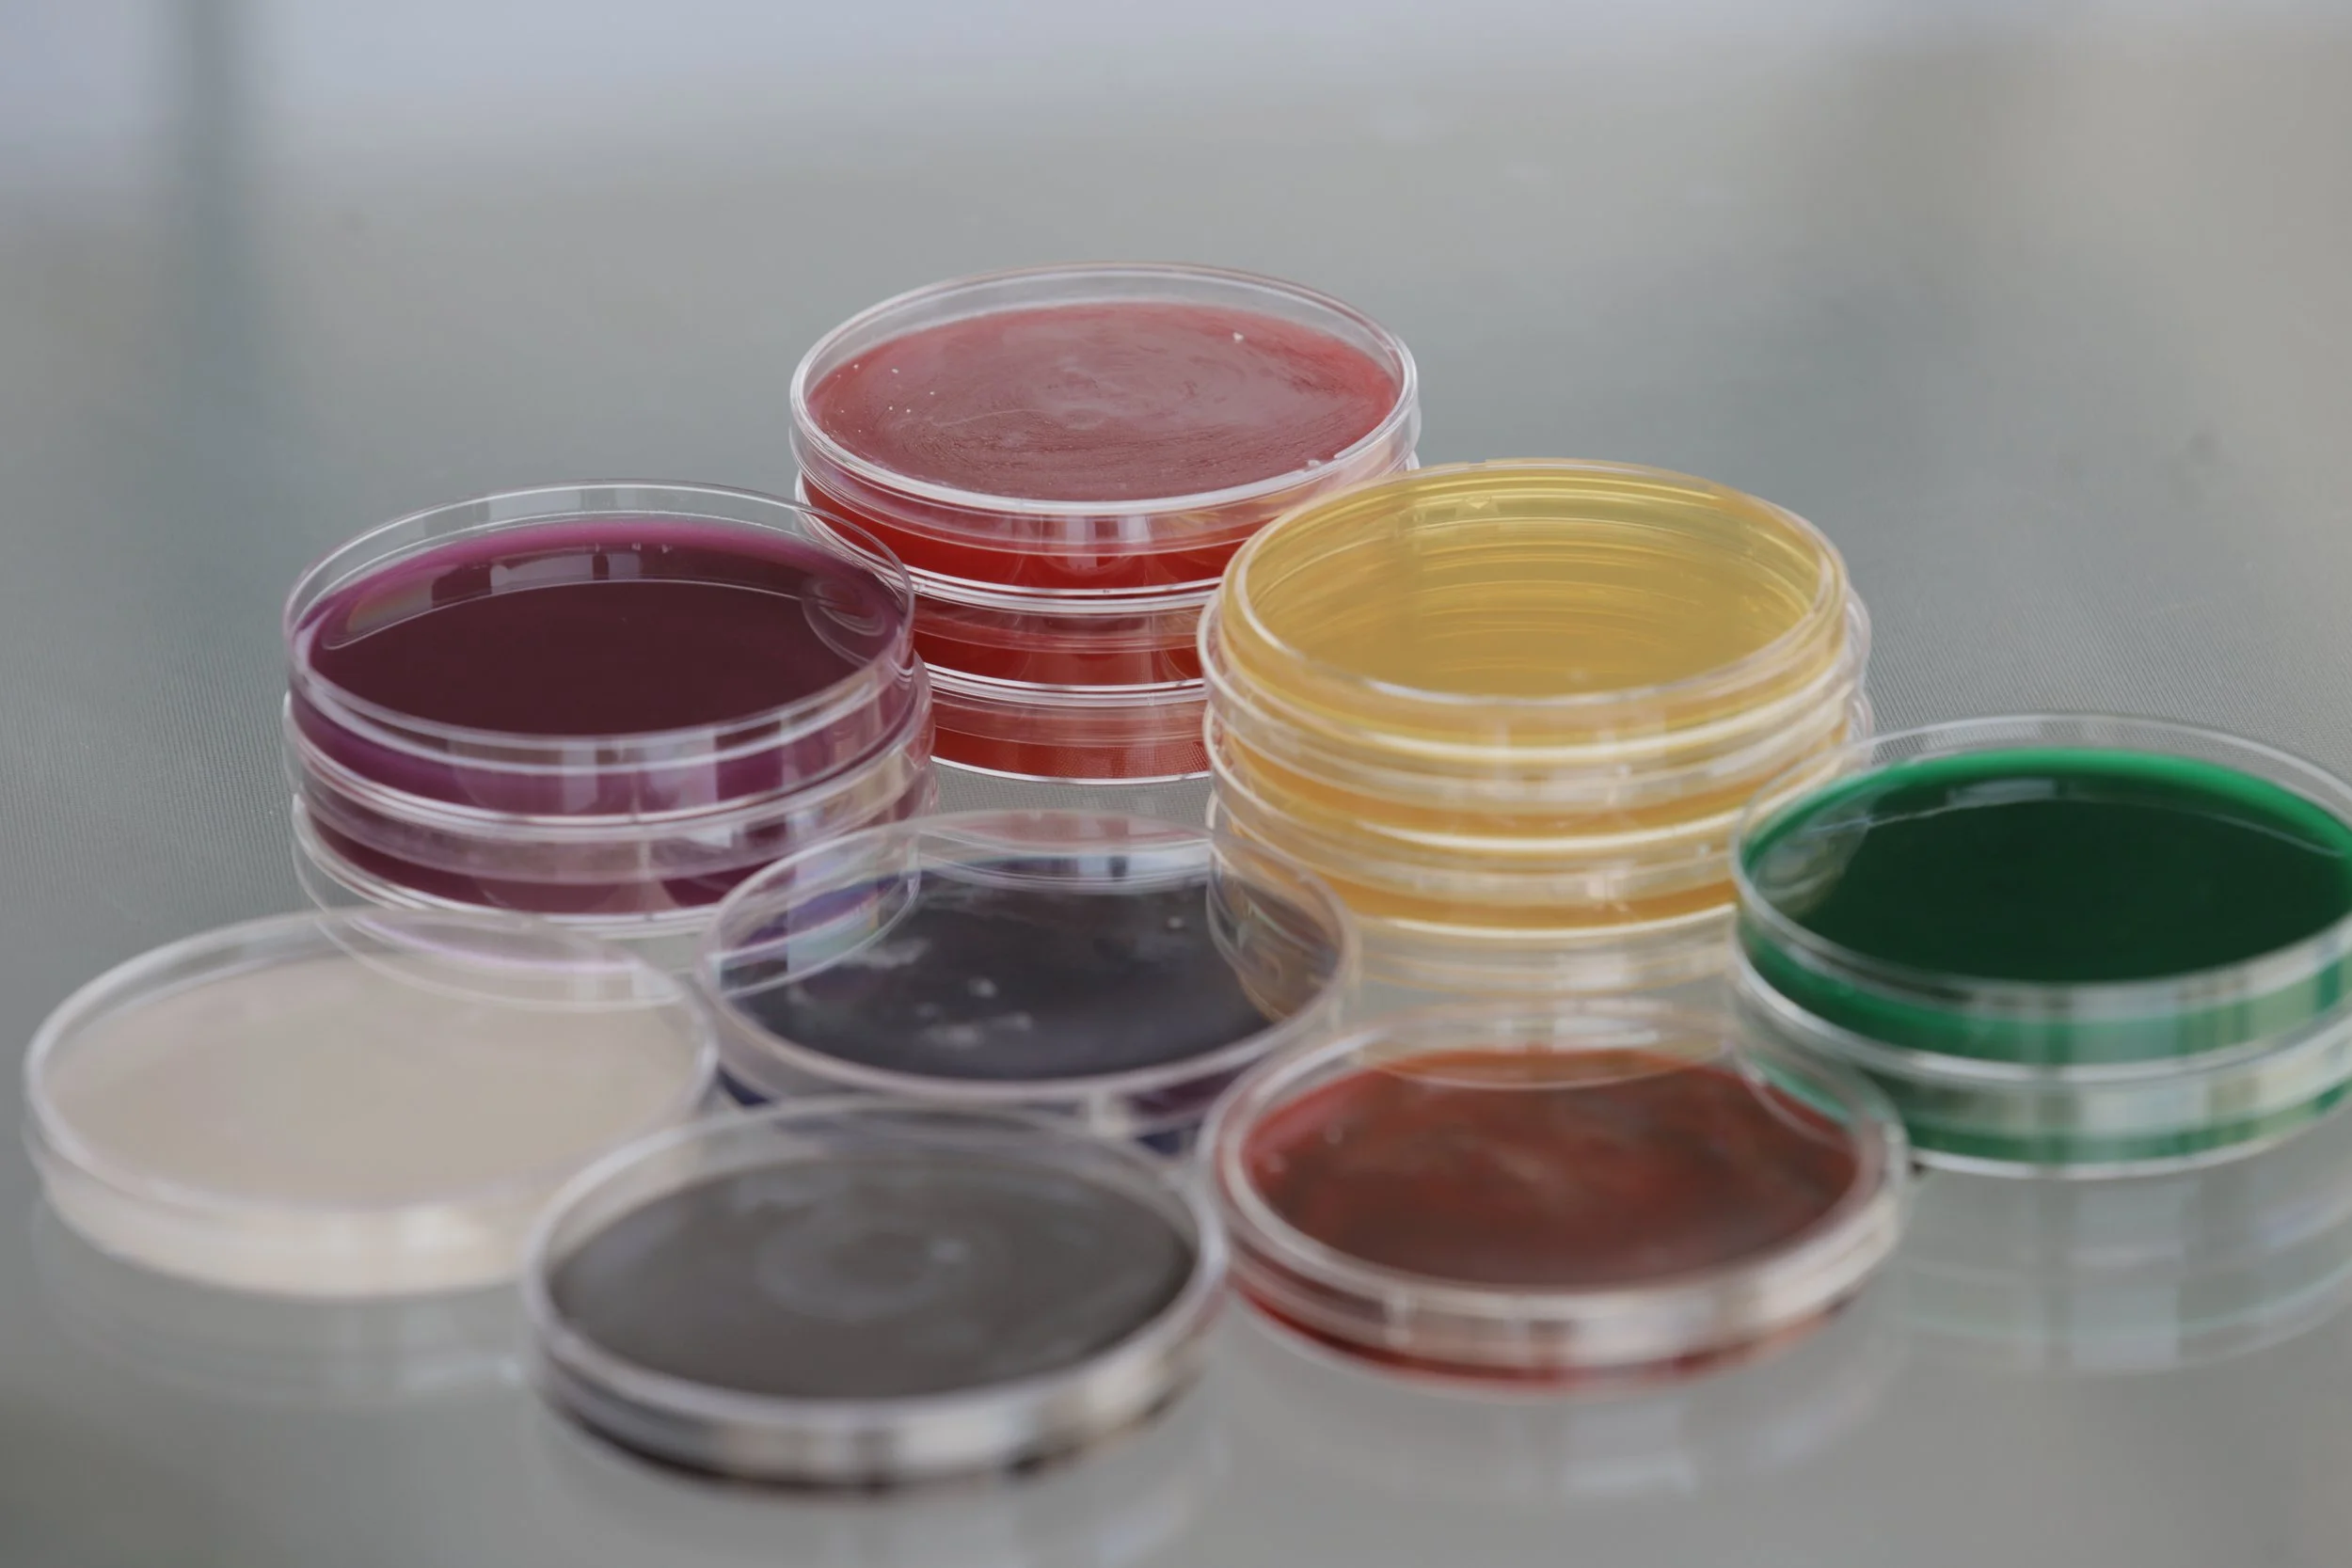

About Us
Who We are
Kumby Consulting is a specialized life science consulting company dedicated to empowering innovation and navigating complexity within the global healthcare sector. We provide expert, strategic services tailored specifically for pharmaceutical, medical device, and biotechnology companies worldwide, helping them achieve their mission-critical goals.
What We Believe
We understand that complex challenges can pose bottlenecks for companies, but we see them as genuine opportunities for growth and advancement. Our primary focus is on leveraging these opportunities to propel our clients forward while fostering a culture of teamwork and continuous improvement.


Our Approach
We work with ambitious life science companies who dare to reimagine today while shaping tomorrow. They are the innovators, game-changers, and leaders who strive to bring science to market. Together, we build reliable, interpretable, and steerable systems that unify operations and help to ensure patients have access to critical therapies where and when they need them.

Expertise

Contamination Control & Sterility Assurance
We offer specialized guidance to manufacturers of regulated medicinal products. Our expertise covers developing and implementing robust controls for microbial, particulate, and chemical contamination across the entire product lifecycle.

Project Management
Project management expertise across multiple projects, including remediation, facility build-outs, and the technology transfer and validation of new manufacturing processes.

Microbiology
Extensive global experience in both hands-on bench work and the management of QC microbiology laboratories across the pharmaceutical, medical device, and biotechnology industries.

Training
Strategically designing and executing QC testing and compliance training programs that guarantee employees consistently receive accurate, standardized instruction.

